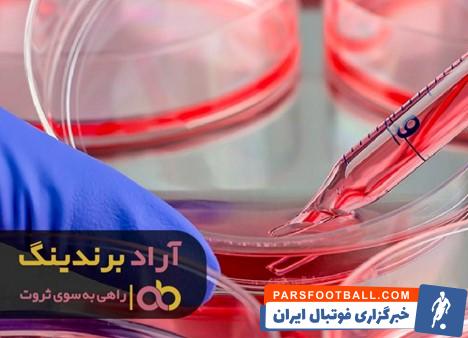
جیوه قرمز در تلفن قدیمی

کدام موارد باعث ثروت آفرینی و موفقیت من شد

مهم ترین عاملی که سبب شد تا به ثروت و موفقیت دست پیدا کنم این بود که مدام در حال تلاش برای پیشرفت کسب و کار خود بودم و از هر موضوعی که می توانست ذره ای مرا در این مسیر یاری دهد کمک گرفتم و در نتیجه توانستم اهداف خود را عملی نمایم.
مهم ترین عاملی که سبب شد تا به ثروت و موفقیت دست پیدا کنم این بود که مدام در حال تلاش برای پیشرفت کسب و کار خود بودم و از هر موضوعی که می توانست ذره ای مرا در این مسیر یاری دهد کمک گرفتم و در نتیجه توانستم اهداف خود را عملی نمایم.
جیوه قرمز در تلفن قدیمی
در عصر جدید تلفن ها به سبک و روش های بسیار پیشرفته تری با فلزات جدید تولید می شوند، مثلا جیوه قرمز در تلفن قدیمی دیگر یافت نمی شود اما اگر یافت می شد این فلز ارزشمند مورد بازیافت قرار می گرفت.
عنصر جیوه کاملا سمی بوده و در مصرف آن باید دقت بسیار زیادی داشت. اگر در حمل و نقل جیوه نهایت دقت وجود نداشته باشد و چند قطره کوچک در آن منطقه وجود داشته باشد
برای جلو گیری از آسیب باید به روش خاص پاکسازی انجام شود. گفته شده که حتی به خاطر این فلز هم تاثیر گذار است و از طریق پوست وارد سلول می شود و بیماری های زیادی ایجاد می کند.
جیوه سیاه
کیمیاگران در پی ساخت طلا با ترکیب ماده جیوه سیاه بودند تا به ثروت کلان برسند و سالها درهمین راستا آزمایشات فراوانی را کرده اند زیرا که معتقد بودن اگر بتوانند جیوه را با ترکیب مواد مختلفی به جامد بودن برسانند حتما به طلا تبدیل خواهد شد. اما امروزه با پیشرفت علم و تکنولوژی متوجه آن شدند که تبدیل به طلا کردن جیوه، خیالی بس اشتباه است.
ولی فلز جیوه، ماده ای بسیار ثروت ساز اما در زمینه پزشکی و یا صنعت می باشد. در صنعت پزشکی از فشار سنج و دماسنج استفاده می شود و فلز جیوه تقریبا با تمام فلزات از جمله طلا و نقره به جز آهن، می تواند آلیاژ بشود. حتی در دندان پزشکی، هم برای عصب کشی و پر کردن دندان ها از ترکیب جیوه استفاده می شود. فقط برای تنفس به خاطر این فلز، کادر درمانی دندان پزشکی باید از تجهیزات مناسب استفاده بکنند تا دچار سرطان نشوند.

جیوه روحانی
جیوه دارای انواعی است مانند جیوه سفید، جیوه روحانی یا سیاه، جیوه قرمز، جیوه خفاش، جیوه رادیو اکتیو و جیوه شاقول.
جیوه سفید نوعی فلز است که در قدیم بسیار با ارزش بوده چون کیمیاگرها آن زمان معتقد بودند این ماده می تواند به طلا تبدیل شود اما امروزه این باور دیگر رد شده است.
جیوه قرمز نوعی دیگر از جیوه با رنگ قرمز و خاصیت تخریب بالا است و در حفاری ها و ساخت بمب اتم کاربرد دارد.
جیوه خفاش، که علت نامگذاری آن به این اسم این بوده که در گذشته معتقد بودند این جیوه در غارهایی که خفاش زندگی می کند وجود دارد و خاصیت شفا بخشی دارد.
جیوه شاقول که به شکل مخروط بوده و به یک طناب وصل است و در گذشته در گنج یاب ها از آن استفاده می کردند.













